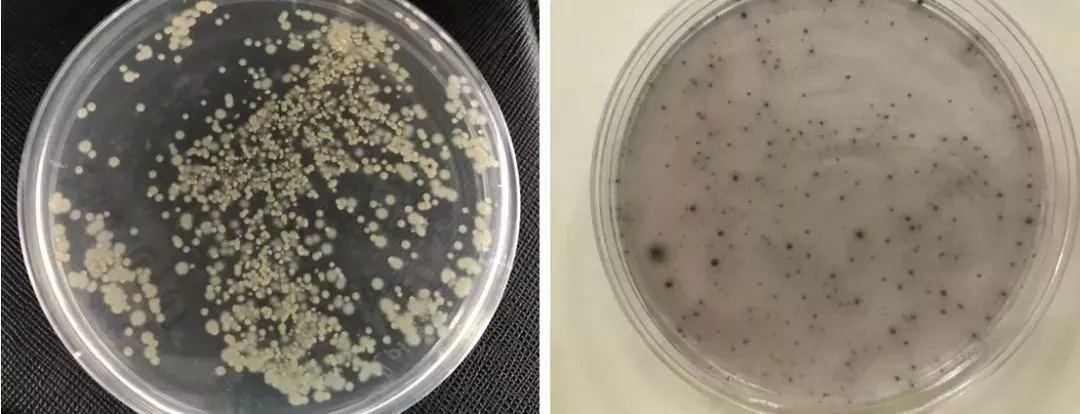

作者: 郑萌 张一梦
法国作家圣埃克苏佩里的《小王子》,是小朋友们和大朋友们都喜欢的一部作品,其中有一句话想必大家耳熟能详——“真正重要的东西,是眼睛看不见的”。今天,咱们就来聊聊一种看不见的“小生命”,以及它和金属“生锈”之间割不断的联系。
1.
举足轻重的“小生命”
微生物是一种看不见、摸不着,但实实在在存在的“小生命”。你知道地球上的微生物有多少吗?告诉你一个惊人的数字,如果将地球上的生物放于天平上称量,微生物占总重量的60%。微生物存在于我们身边,就连我们体内都存活着大量的微生物。如果将生存于我们身体的所有微生物集中起来称重,能占到我们体重的3%——也就是说60公斤的大人体内,竟然有1.8公斤的“小生命”存活着呢。
最大的微生物尺度约为100~750μm,而最小的微生物只有10nm左右。例如,大肠杆菌为杆状,它们的长度约2~3 μm,300~500只大肠杆菌排成直线才有大约1mm的长度。
微生物有好的也有坏的。大肠杆菌是肠道中最主要且数量最多的一种细菌,如果其中致病性的一类大量繁殖,会让人拉肚子。我们喝的酸奶里常添加的保加利亚乳杆菌和嗜热链球菌等等,则是一类有益菌。它们可以促进消化吸收,提高机体免疫,还能抑制有害菌的生长。青霉素则可以称得上“拯救人类的真菌”。1928年英国细菌学家弗莱明发现青霉素,迈出了造福人类的第一步;1940年澳大利亚病理学家弗罗理和德国化学家钱恩对青霉素进行提纯并应用于医疗,拯救了无数人的生命。
图1 实验室培养的海洋微生物(马岩博士 拍摄)
(左:珊瑚表面分离纯化的细菌;右:海中金属生锈层中分离纯化的细菌)
2.
微生物如何“吃掉”金属
很久以来,这些“小生命”的另外一种作用——对金属腐蚀的影响都是科学家研究的一项课题。金属腐蚀,也就是我们常说的“生锈”,是金属在环境中发生的一类化学和电化学反应。它不仅会导致设施设备的结构损伤,缩短其寿命,还可能引起突发性灾难事故,污染环境,或造成重大财产损失和人员伤亡。
2001年,宜宾金沙江大桥吊杆发生腐蚀断裂,部分桥面垮塌,造成多人伤亡,经济损失数千万元;2013年11月,山东黄岛发生爆炸事故,造成62人死亡、136人受伤,直接经济损失超过7.5亿元。调查报告指出,该事故直接原因是“输油管道与排水暗渠交汇处管道腐蚀减薄、管道破裂、原油泄漏”,撞击火花引发油气爆炸。这些都是腐蚀的危害。经过我国各行业专家长达两年多的调查,2014年我国腐蚀成本约为21,278亿元,这是一项非常惊人的经济损失。

图2 金属的“生锈”带来的危害超过自然灾害总和
那么,金属“生锈”是怎么和咱们身边这些看不见的“小生命”搭上界的呢?这是因为微生物的生存和繁殖,会改变金属表面的环境,例如氧气浓度、酸碱度,各种离子浓度还有导电性等等,而这些因素都可以对金属腐蚀产生影响。在水溶液中,细菌和其他微生物会在金属表面形成一层薄薄的生物膜,在这个生物膜中会发生大量的化学反应。所以说这些“小生命”也开起了一间间工厂呢。
举例来说,有一类叫做硫酸盐还原菌的“小生命”,这类细菌能把一些硫酸盐通过代谢进行还原。它不是一种细菌,而是一类细菌的统称,在大自然中的各种各样的环境中都生活着,例如海水、河水、土壤还有油田等等,在自然界硫的化学循环中发挥着重要的作用。一般来说,硫酸盐还原菌可以加速钢铁的腐蚀。
关于它加速腐蚀的原理,科学家们有过各种各样的解释。有些人认为,硫酸盐还原菌代谢可以产生硫化氢和一些生物有机硫化物,它们和环境中的腐蚀离子产生协同作用,这种酸度环境会加速金属的腐蚀;还有一些人认为,硫酸盐还原菌的代谢可以吸收铁原子里面的电子,促进铁原子失去电子变成铁离子,也就促进了腐蚀的化学反应。这些小生命不但能够加速铁的腐蚀,对不锈钢也不“示弱”,实验证明,它的生长和代谢可以让不锈钢的钝化作用降低。

图3 显微镜下金属表面的硫酸盐还原菌(段继周研究员 拍摄)

图4 硫酸盐还原菌让腐蚀更严重的一种解释
(图片来源:中国科学院海洋研究所陈士强博士学位论文)
当然,微生物对腐蚀的影响也不能一概而论。比方说,含有微生物的生物膜在金属表面也能够形成有机障碍层,从而对腐蚀的化学反应起到隔断作用;另外,有一些消耗氧气的细菌,可以降低金属表面氧的浓度,而氧气又是金属腐蚀所必须的。所以说,很多情况下,生物膜可以减少金属大面积的均匀腐蚀。不过,个别的微生物品种还是容易造成金属的局部腐蚀,导致金属生成小孔或发生断裂等等,其威力也不可小视呢。

图5 碳钢浸泡在硫酸盐还原菌海水里产生小腐蚀坑
(图片来源:中国科学院海洋研究所陈士强博士学位论文)
近些年,科学家们在关于细菌(包括厌氧菌和耗氧菌等)对金属腐蚀影响方面的研究,取得了越来越深入的成果。我们也期待有一天,人类能够调节和利用这些生活在金属表面的“小生命”,让它们更好地保护金属而不是“吃掉”金属。
(本文中标明来源的图片均已获得授权)
出品:科普中国
制作:中国科学院海洋研究所 海洋环境腐蚀与生物污损重点实验室科技部国家海洋腐蚀防护工程技术研究中心郑萌 张一梦
监制:中国科学院计算机网络信息中心
本文来源于“中国科普博览”公众号(kepubolan),转载请注明公众号出处



评论